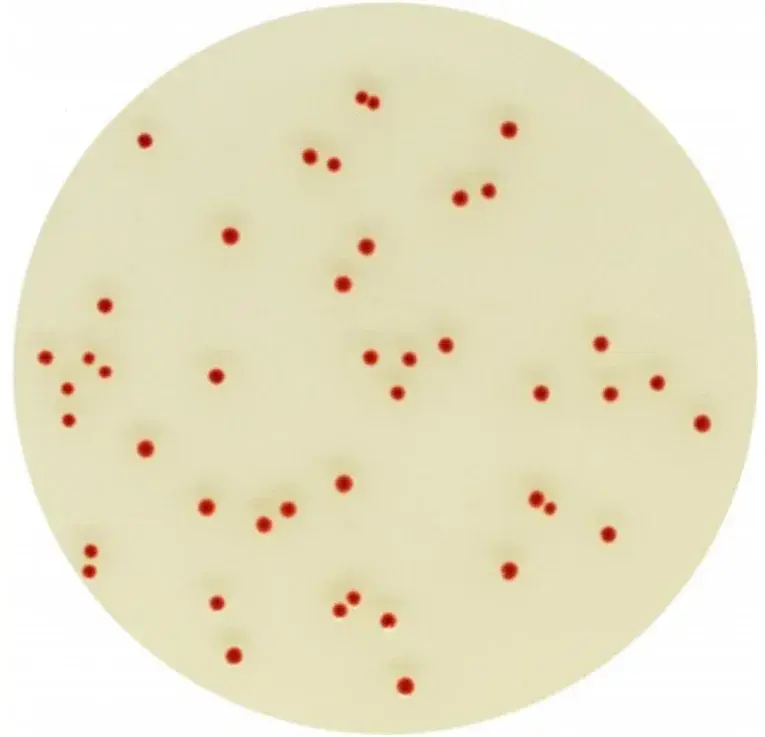
Chromagar Campylobacter 10 Adet

Chromagar Campylobacter 10 Adet
667,12 TL
*68,46 TL den başlayan taksitlerle!
CHROMagar Campylobacter 10 Adet, mikrobiyoloji laboratuvarlarında kullanılan hazır bir besiyeridir. Bu ürün, Campylobacter türlerini izole etmek ve tanımlamak için özel olarak formüle edilmiştir. Ürün, CHROMagar'ın güvenilirliği ve kalitesiyle üretilmiştir.
Ürün Özellikleri:
- Özel formülasyonu ile Campylobacter türlerini başarılı bir şekilde besiyerinde izole etme imkanı
- Kullanımı kolay ve pratik bir şekilde 10 adet olarak sunulmuştur
- Mikroorganizmaların kolonilerini farklı renklerde ve karakteristik şekillerde belirginleştirme özelliği
- Yüksek kaliteli malzemeler kullanılarak üretilmiştir
- Laboratuvar çalışmalarında güvenilir sonuçlar elde etmek için ideal bir seçenektir
Bu ürüne ilk yorumu siz yapın!